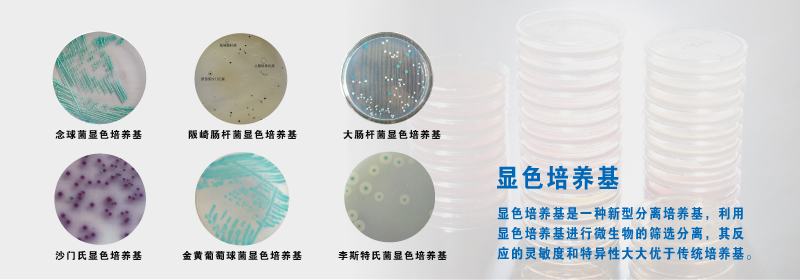

昀冠新聞
合作丨上海昀冠攜手海博生物,助力科研研究
2023-03-12昀冠科學商城新聞編輯
今年,上海昀冠生物科技有限公司與青島海博生物技術有限公司達成合作伙伴關系,成為海博生物的代理商。
2023年2月,上海昀冠與海博生物達成合作伙伴關系,成為海博生物的代理商。根據協議,海博生物科研領域的食品衛生檢驗系列、中國藥典培養基、臨床檢驗系列、生化鑒定系列、化妝品檢驗、一次性衛生用品檢驗、生活飲用水和水源水、驗、飲用天然礦泉水檢驗、塑料防霉劑防霉效果評估、軍團菌檢測、植物組織培養等產品,將由上海昀冠代理和銷售。
主要產品

青島高科技工業園海博生物技術有限公司
青島高科技工業園海博生物技術有限公司(以下簡稱海博生物公司)注冊成立于2000年2月1日,法人代表:蔡向榮。公司位于美麗的海濱城市——青島,是集研發、生產和銷售于一體的高新技術企業,為國家檢驗檢疫機構、食品、醫藥、生物研究、化妝品、水質和臨床檢驗等領域提供微生物檢測產品支持與服務。
海博生物公司自成立以來就專注于微生物培養基的研發和生產,產品包括微生物干粉培養基、顆粒培養基、顯色培養基、即用型培養基、動物疫苗培養基、植物組織培養基、細胞培養基和各種配套試劑,品種多達1000多種,是國內微生物產品品種最全的廠家之一。產品嚴格按照GB標準、SN標準、中國藥典標準、WS標準、YY/T標準、ISO標準、FDA標準、日本標準、USP標準、EP標準、BP標準等國內外標準生產制作和質量控制。
公司配有一個裝備完善的實驗室和標準化的廠房,擁有一流的技術人員、成熟的研發團隊,一整套嚴格的品質監控體系,確保培養基的技術先進性和質量穩定性。

滬公網安備31011502401370


